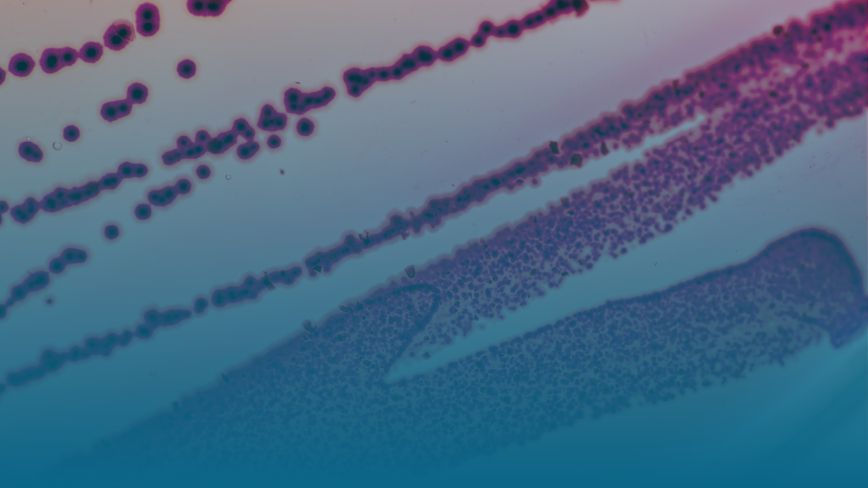

SVG

Antimicrobial Resistance (AMR)
Antimicrobial resistance (AMR) has been called the silent pandemic. FasterCures seeks to encourage the development of new antibiotics by promoting policies that could incentivize drug developers, investigate ways to bring more private capital into the space, and highlight emerging approaches to treating bacterial infections beyond antibiotics.
Antimicrobial Resistance (AMR)
Related Articles
-
On the Zero-Draft Resolution of the “Scope, modalities, format and organization of the High Level Meeting on Antimicrobial Resistance convened by the President of the General Assembly”
On behalf of the Milken Institute’s FasterCures, we would like to express our strong support for current initiatives taking place globally that seek to address the threat of antimicrobial resistance (AMR). As a part of the Milken Institute...Read Letter -
Pandemic and All-Hazards Preparedness Act (PAHPA) Reauthorization Discussion Draft - US Senate HELP Committee
Thank you for the opportunity to provide comments on the discussion draft of the Pandemic and All-Hazards Preparedness Act (PAHPA) reauthorization, the first reauthorization since the COVID-19 global pandemic and mpox outbreak. We commend...Read LetterImage
Esther Krofah
Executive Vice President, Milken Institute HealthEsther Krofah is the executive vice president of Health at the Milken Institute, leading FasterCures, Public Health, the Future of Aging, and Feeding Change. A recognized expert in health policy, biomedical innovation, and clinical research, Krofah has extensive experience shaping health initiatives that unite diverse stakeholders, foster collaboration, and motivate action toward shared goals. -

Models for Financing Antibiotic Development to Address Antimicrobial Resistance
The Financial Innovations Labs® and FasterCures teams have collaborated on a project to identify new models for financing the antimicrobial resistant antibiotic pipeline. These past 18 months have demonstrated how consequential public...Read Report

Related Videos
-
 A Global Priority: The Fight Against Antimicrobial Resistance2023 Future of Health Summit Session Part 1
A Global Priority: The Fight Against Antimicrobial Resistance2023 Future of Health Summit Session Part 1 -
A Conversation with US Senators Michael Bennet, Colorado and Todd Young, Indiana2023 Future of Health Summit Session Part 2
A Conversation with US Senators Michael Bennet, Colorado and Todd Young, Indiana2023 Future of Health Summit Session Part 2 -
 What’s Next for the UK’s Subscription Model in the Fight Against Antimicrobial Resistance2023 FasterCures Webinar
What’s Next for the UK’s Subscription Model in the Fight Against Antimicrobial Resistance2023 FasterCures Webinar -
 Reviving the Antibiotic Pipeline: How Can New Investments and Incentives Beat Superbugs?2021 Global Conference Session
Reviving the Antibiotic Pipeline: How Can New Investments and Incentives Beat Superbugs?2021 Global Conference Session -
 Are Resistant Infections the Next Pandemic? New Antibiotics Need New Incentives2020 Future of Health Summit Session
Are Resistant Infections the Next Pandemic? New Antibiotics Need New Incentives2020 Future of Health Summit Session -
 Superbugs: Avoiding an Existential Threat to Humanity2018 London Summit Session
Superbugs: Avoiding an Existential Threat to Humanity2018 London Summit Session

